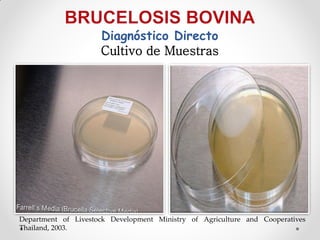
Diagnóstico Directo
                     Cultivo de Muestras




Department of Livestock Development Ministry of Agriculture and Cooperatives
Thailand, 2003.

Este documento resume un estudio epidemiológico sobre la brucelosis humana en el noroeste de Ecuador entre 1996 y 2008. Analiza la distribución de muestras y factores de riesgo. De 3733 muestras, 104 dieron positivo (2,78%). La mayoría de casos positivos fueron hombres (60,58%) entre 16 y 45 años (68,27%). El estudio provee información valiosa sobre la epidemiología de la brucelosis humana en la región.